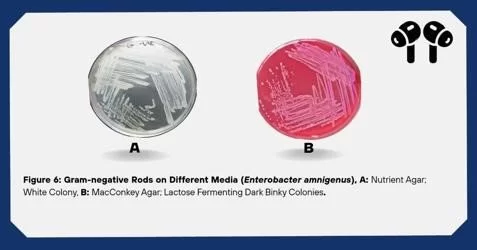

تميز طلاب قسم علم النبات بكلية العلوم فى تقديم الحلقة الدراسية
في إطار المتابعة الدروية لطلاب الاجازة العالية الماجستير فقد قام قسم علم النبات بكلية العلوم صباح اليوم الاحد الموافق 15 فبراير 2026م بقاعة مناقشات الدراسات العليا رقم 2 بتقييم النشاط البحثي لبعض الطالبات والذي تزامن مع موعد تقديمهن للحلقة الدراسية رقم 2 وهن:
الطالبة: ملاك الرحمة عبدالرزاق الفطيسي
إشراف: د. حليمة عبدالله نشنوش و د. ربيعة عبدالقادر الاحمر
الطالبة: نشوى صلاح المختار الغول
إشراف د. حليمة عبدالله نشنوش
وقد نالت العروض استحسان الاساتذة المشرفين ولجنة الدراسات العليا بالقسم والحضور. وتتميز اغلب البحوث التى يقوم بها القسم بعلاقتها بالواقع وارتباطها بالبيئة المحلية مما يعطيها بعداً مهماً فى دراسة ومعالجة القضايا المحلية. ويتقدم السيد رئيس قسم علم النبات د. فتحي الصغير والسيد أ. د. خالد المرغني مدير مكتب الدراسات العليا والتدريب بالكلية باسمى ايات الشكر والتقدير للاساتذة المشرفين على البحوث العلمية آملين مزيد البذل والعطاء فى خدمة المجتمع وإثراء البحث العلمي والتى تعتبر نقطة مضيئة فى ظل الظروف التى تمر بها بلادنا.

التعليقات